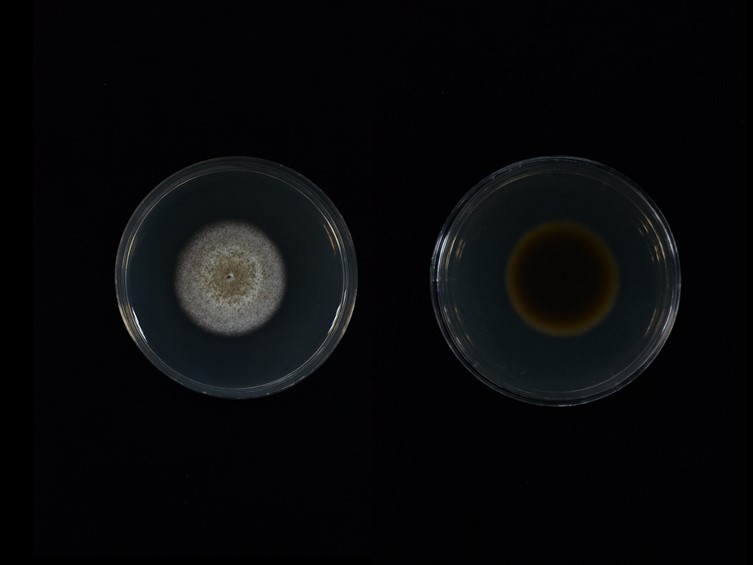

Holotype:
THAILAND, Kalasin Province, Khok Pa Si Community Forest, 8 Jun. 2021, A. Khonsanit, D.Thanakitpipattana, K. Tasanathai, holotype MY12719, ex-type living culture BCC 95830.
Habitat:
Buried in soil.
Host:
On Coleoptera larvae.
Description:

Stromata single or double on Coleoptera larvae, brown, dark brown to black, cylindrical, slightly curved to curved, emerging from the fallen off feet pairs of the larva, 5.5–10 cm long and 2–3 mm broad, enlarging abruptly at the 
fertile head. Fertile head terminal, brown to dark brown, ovoid, limoniform, with ostioles slightly protruding on the surface of the fertile stroma, 5–7 mm long and 3–4 mm broad. 
Perithecia pseudo-immersed, obclavate, 630–820 × 210–300 μm. 
Asci cylindrical, 305–525 × 4.5–5.5 μm. Asci-caps convex, 3–4 × 5–5.5 μm. 
Ascospores filiform, multi-septate and breaking into 64 part-spores, 430–615 × 1–2 μm. Part-spores cylindrical with truncated apices, 5–20 × 1–2 μm.
Culture characteristics:
Colony on PDA attaining a diam of 2.7–3 mm in white light/dark cycles for 4 wk at 25 °C, brown in the middle and white at the margins, colony reverse dark brown in the middle and brown at the margins. Conidial structures consisting of erect conidiophores arising from the aerial hyphae. 
Phialides solitary, smooth-walled, elongate-ampulliform and truncated at the base 7–38 × 2–4 μm. 
Conidia cylindrical with rounded ends, ellipsoid, fusoid and ovoid, white to cream, 3–12 × 2–4 μm.
Reference:
Crous PW, Osieck ER, Shivas RG, et al. (2023). Fungal Planet description sheets: 1478–1549. Persoonia 50: 158–310.
DOI: https://doi.org/10.3767/persoonia.2023.50.05Species |
Strain |
Compound |
Pubchem CID |
Biological activity |
Reference |
|---|
|
Strain |
OQ627396 |
|---|---|
| BCC 95830 | OQ627397 |